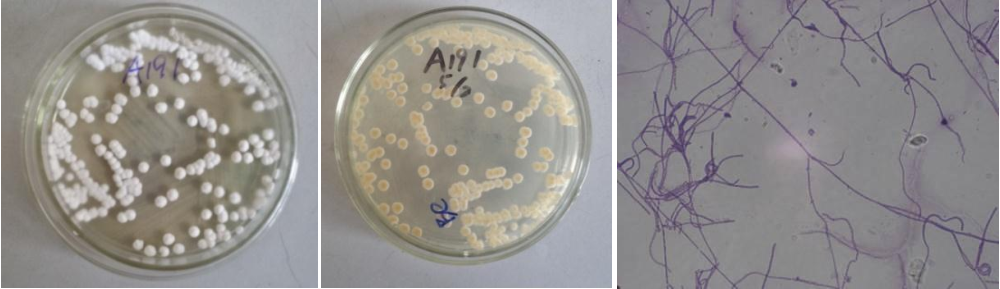

Loading...
| StrainNO | A191 |
| Classification | Streptomyces |
| 16s rDNA sequence | |
| Strain Morphology Photos | |
| Morphological Description | hyphae branch;apart;mycelium thicker and shorter;protoplast condensation in old filaments;spore filaments straight or curved;with few spirals;spore barrel or nearly round;spore pile lotus white;back s |